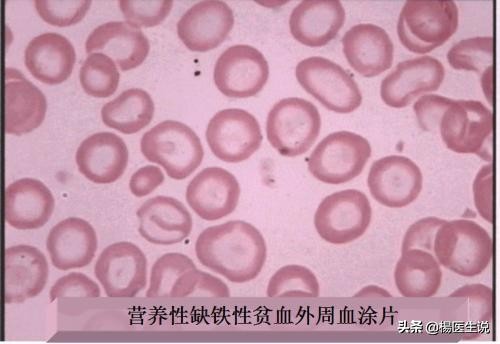
儿童贫血看血常规哪个指标,缺铁性贫血血常规看哪几项

贫血了,血常规可以看得出吗?
在杨医生的日常工作中,我经常听到许多朋友抱怨医生开的检查太多了,在许多情况下还特别的看不起咱检验科。他们认为检验科许多检查项目都没有必要,听到这些话作为检验科医生真的不是滋味,或许在他们眼里只有骨科的那种说截就截,说换就换来的更实际一些。至少这样做他们实实在在看到了,就拿我们最为基本的血常规来说,都经常被喷得一无是处!

血常规是很普通同时也是非常有价值的一个检查项目,血常规实际上就是对外周血进行细胞分析。在很早之前大多机器都只能做三分类血球分析,但是随着科学技术的发展,现在五分类血球基本已经普及,并且成了日常诊疗中最基本的一个检查项目。
现在我们来看一个贫血的案例,看看血常规到底能看出什么名堂?
病例:患者,10岁,女性,面色苍白就诊。实验室血常规检查:仪器检测Hb77g/L(正常不能低于110),RBC3.52X 10^12/L(正常不能低于3.6), Hct 0. 247(正常不能低于0.36),MCV64.7f1(正常不能低于80), MCH 20.2pg(正常不能低于27),MCHC 312g/L(正常不能低于320),RDW-SD40.2fl(正常不能低于35),RDW-CV14.1%(正范围11.4-14.5)。RBC的P信息提示: Anemia(贫血)、Hypochromia(低色素性) Anisocytosis(小红细胞增多)等。为了更加确定细胞分型,我们进行血涂片人工显微镜观察发现:成熟红细胞大小较均一,但明显偏小,无淡染区增大,但易见靶形红细胞。
根据患者血常规分析结果可以看出血红蛋白较低,红细胞,MCV,MCH,MCHC均低于正常值。患者实际情况,和各项检查指标,其实我们可以基本判断该患者为小细胞低色素贫血,这种贫血也叫做缺铁性贫血。

缺铁性贫血( iron deficiency anemia,IDA)早期诊断和疗效观察:鉴于95%以上的IDA的RDW均异常,一般认为,如果患者血液检查表现为小细胞低色素性贫血而RDW正常,此类患者患IDA的可能性不大;但是IDA在缺铁潜伏期时RDW即有增高,治疗后,若贫血纠正,但RDW仍未降至正常水平,可能反映体内铁未完全补足。
因此临床上要做好IDA和轻型B地中海贫血之间的鉴别:由于Hb合成障碍,DA和轻型B地中海贫血均可表现为小细胞低色素贫血,前者红细胞形态明显大小不等,RDW增高;后者大小较均RDW基本正常。

上表是各种贫血对比,这些都是血常规能分析计算出来的结果,在临床上都有非常大的参考价值!